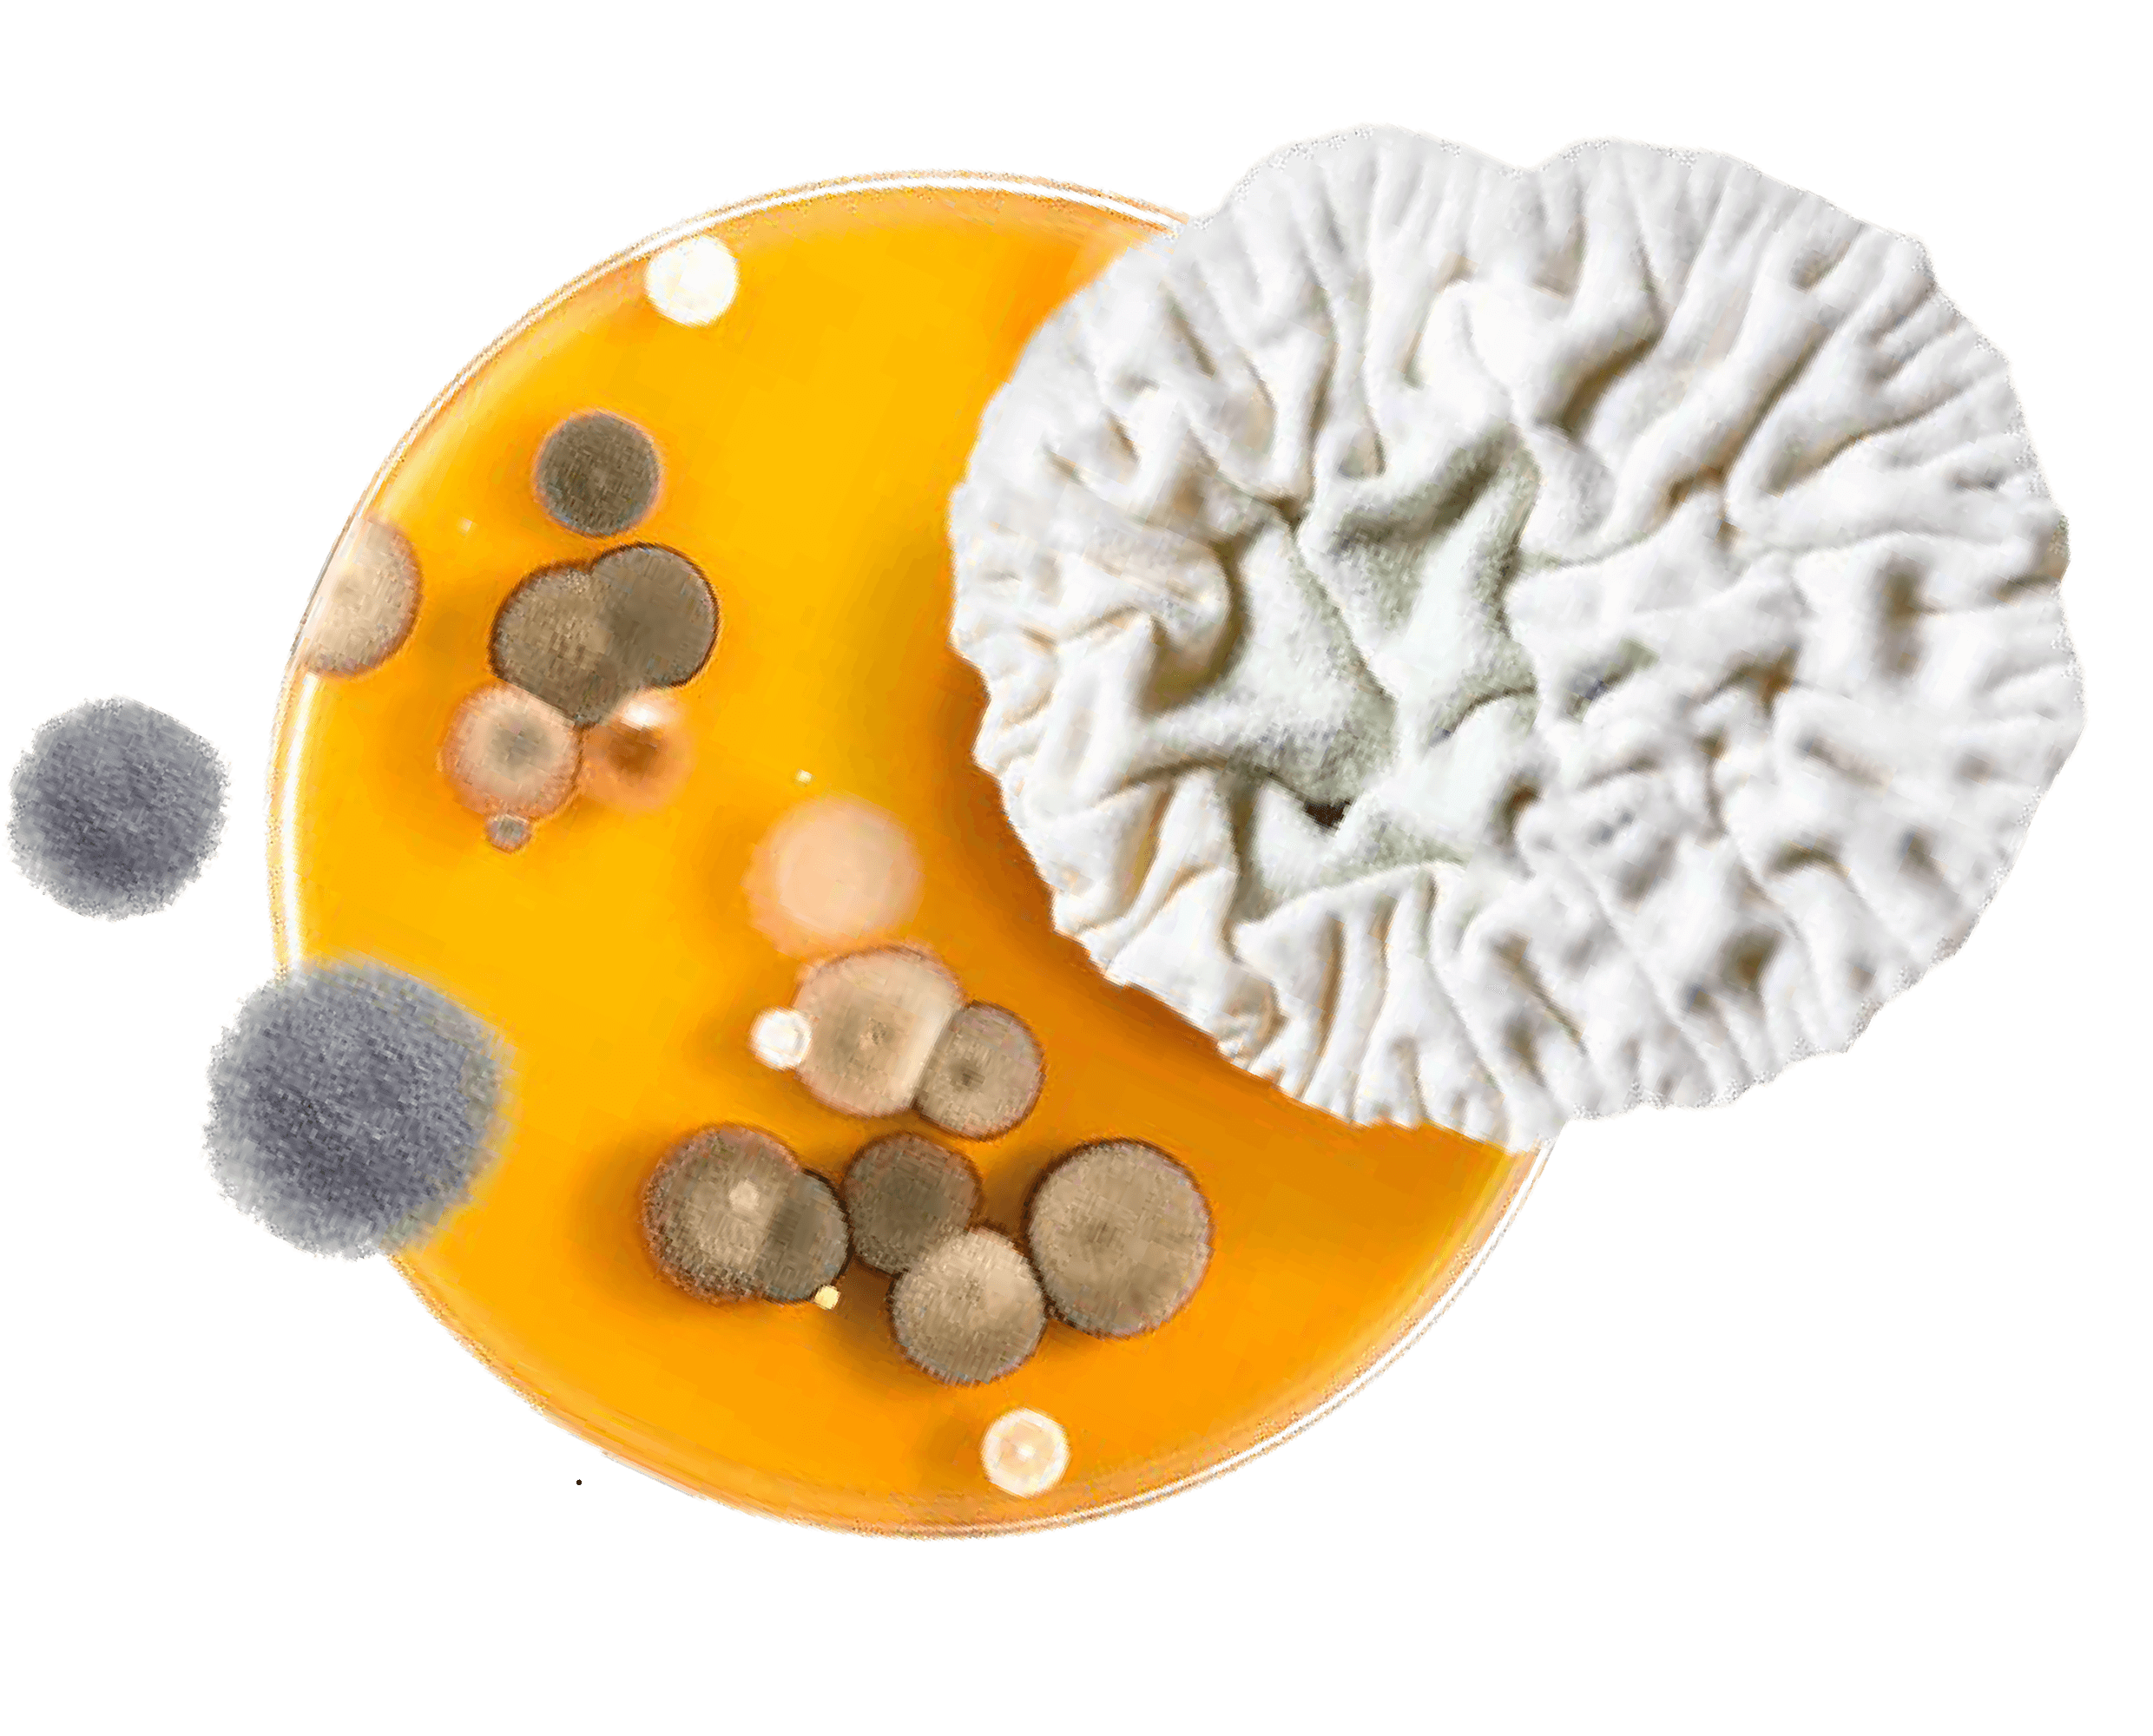

- All
- Mivena (Holland)
- GelAgro (Bulgaria)
- Organiberia (Spain)
-

Granusol
MV10 20 + 20 + 20 + 1MgO + traces
Provider: Mivena
Nationality: Holland
Dose: 3gm / 1L
Mivena manufactures Granusol Granusol WSF contains trace ele and ease of absorption into plant Granusol Crystral technology ens a temperature of 8°C Granusol irrigation. All of the above was c as the method of manufacturing complete and fast absorption an Mivena manufactures Granusol WSF brand which is a 100% crystalline fertilizer. Beside N, P, K, (major elements) Granusol WSF contains trace elements in the chelated forms EDTA, DTPA and EDDTA this is to ensure complete and ease of absorption into plants and soil at rates much higher than other products in the market. Granusol Crystral technology ensures complete solubility of the product in water by 100%, starting at a temperature of 8°C. Granusol WSF is suitable for all kinds of irrigation like: fertigation, pivot, drip and normal irrigation. All of the above was combined with the new patent for the new technology under the name (MV10), as the method of manufacturing this technology contains extremely important additives that guarantees complete and fast absorption and remarkable effects on plant
Content:
Nitrogen (N)
0.4 % ammonium nitrogen
4,1 % nitrate nitrogen20 % Phosphate (p2O5),(8,7 % P)
soluble in water20 % Potassium Oxide (K2O), (16,6% K)
soluble in water20 % Magnesium Oxide (MgO), (0,6% Mg)
soluble in water1 % Boron (B) 0,020 % Copper (Cu), EDTA 0,015 % Iron (Fe),
0,05% Fe, EDTA
0,05% Fe, DTPA
0,02% Fe, EDDHA0,0120 % Manganese (Mn), EDTA 0,060 % Molybdenum (Mo) 0,010 % Zinc (Zn), EDTA 0,015 % -

Granusol
MV10 4.5+11+36+5MgO+10s+traces
Provider: Mivena
Nationality: Holland
Dose: 3gm / 1L
Mivena manufactures Granusol Granusol WSF contains trace ele and ease of absorption into plant Granusol Crystral technology ens a temperature of 8°C Granusol irrigation. All of the above was c as the method of manufacturing complete and fast absorption an Mivena manufactures Granusol WSF brand which is a 100% crystalline fertilizer. Beside N, P, K, (major elements) Granusol WSF contains trace elements in the chelated forms EDTA, DTPA and EDDTA this is to ensure complete and ease of absorption into plants and soil at rates much higher than other products in the market. Granusol Crystral technology ensures complete solubility of the product in water by 100%, starting at a temperature of 8°C. Granusol WSF is suitable for all kinds of irrigation like: fertigation, pivot, drip and normal irrigation. All of the above was combined with the new patent for the new technology under the name (MV10), as the method of manufacturing this technology contains extremely important additives that guarantees complete and fast absorption and remarkable effects on plant
Content:
Nitrogen (N)
0.4 % ammonium nitrogen
4,1 % nitrate nitrogen4.5 % Phosphate (p2O5),(4.8 % P)
soluble in water11 % Potassium Oxide (K2O), (29,9% K)
soluble in water36 % Magnesium Oxide (MgO), (3% Mg)
soluble in water5 % Sulfur (S) 10 % Boron (B) 0,020 % Copper (Cu), EDTA 0,015 % Iron (Fe),
0,05% Fe, EDTA
0,03% Fe, DTPA
0,005% Fe, EDDHA0,085 % Manganese (Mn), EDTA 0,025 % Molybdenum (Mo) 0,004 % Zinc (Zn), EDTA 0,025 % -

Granusol
MV10 12+7+25+8CaO+2MgO+traces
Provider: Mivena
Nationality: Holland
Dose: 3gm / 1L
Mivena manufactures Granusol Granusol WSF contains trace ele and ease of absorption into plant Granusol Crystral technology ens a temperature of 8°C Granusol irrigation. All of the above was c as the method of manufacturing complete and fast absorption an Mivena manufactures Granusol WSF brand which is a 100% crystalline fertilizer. Beside N, P, K, (major elements) Granusol WSF contains trace elements in the chelated forms EDTA, DTPA and EDDTA this is to ensure complete and ease of absorption into plants and soil at rates much higher than other products in the market. Granusol Crystral technology ensures complete solubility of the product in water by 100%, starting at a temperature of 8°C. Granusol WSF is suitable for all kinds of irrigation like: fertigation, pivot, drip and normal irrigation. All of the above was combined with the new patent for the new technology under the name (MV10), as the method of manufacturing this technology contains extremely important additives that guarantees complete and fast absorption and remarkable effects on plant
Content:
Nitrogen (N)
12 % nitrate nitrogen12 % Phosphate (p2O5),(3,1 % P)
soluble in water7 % Potassium Oxide (K2O), (20,7% K)
soluble in water25 % Calcium Oxide (CaO), (5,7% Ca)
soluble in water8 % Magnesium Oxide (MgO), (1.2% Mg)
soluble in water2 % Boron (B) 0,010 % Copper (Cu), EDTA 0,010 % Iron (Fe),
0,085% Fe, EDTA
0,020% Fe, DTPA
0,015% Fe, EDDHA0,120 % Manganese (Mn), EDTA 0,025 % Molybdenum (Mo) 0,004 % Zinc (Zn), EDTA 0,008 % -

Granusol
MV10 10+52+10+1MgO+traces
Provider: Mivena
Nationality: Holland
Dose: 3gm / 1L
Mivena manufactures Granusol Granusol WSF contains trace ele and ease of absorption into plant Granusol Crystral technology ens a temperature of 8°C Granusol irrigation. All of the above was c as the method of manufacturing complete and fast absorption an Mivena manufactures Granusol WSF brand which is a 100% crystalline fertilizer. Beside N, P, K, (major elements) Granusol WSF contains trace elements in the chelated forms EDTA, DTPA and EDDTA this is to ensure complete and ease of absorption into plants and soil at rates much higher than other products in the market. Granusol Crystral technology ensures complete solubility of the product in water by 100%, starting at a temperature of 8°C. Granusol WSF is suitable for all kinds of irrigation like: fertigation, pivot, drip and normal irrigation. All of the above was combined with the new patent for the new technology under the name (MV10), as the method of manufacturing this technology contains extremely important additives that guarantees complete and fast absorption and remarkable effects on plant
Content:
Nitrogen (N)
7.5 % ammonium nitrogen
0.2 % nitrate nitrogen
2.3 % urea nitrogen10 % Phosphate (p2O5),(22,7 % P)
soluble in water52 % Potassium Oxide (K2O), (8,3% K)
soluble in water10 % Magnesium Oxide (MgO), (0,6% Mg)
soluble in water1 % Boron (B) 0,020 % Copper (Cu), EDTA 0,015 % Iron (Fe),
0,050% Fe, EDTA
0,030% Fe, DTPA
0,005% Fe, EDDHA0,085 % Manganese (Mn), EDTA 0,025 % Molybdenum (Mo) 0,004 % Zinc (Zn), EDTA 0,025 % -

FERT STAR
20-20-20+ME
Provider: GelAgro Group
Nationality: Bulgaria
Dose: 3gm / 1L
FERT STAR 20-20-20+ TE is a powdered water-soluble fertilizer, providing balanced plant nutrition. This fertilizer is suitable for use during the growing season
Content:
Nitrogen (N) 20 % Phosphorus pentoxide (P2O5) 20 % Potassium Oxide (K2O) 20 % Iron (Fe) 0.03 % Manganese (Mn) 0.04 % Zinc (Zn), EDTA 0,04 % Copper (Cu), EDTA 0,02 % Boron (B) 0,02 % Molybdenum (Mo) 0,002 % -

FERT STAR
30-10-10+ME
Provider: GelAgro Group
Nationality: Bulgaria
Dose: 3gm / 1L
FERT STAR 30 - 10 - 10 + ME is a powdery water-soluble fertilizer with a high nitrogen content.
Nitrogen is a major building block of proteins and is part of many other important organic compounds.
It is part of many biochemical processes that are essential during the growing season - leaf formation, photosynthesis, fruit formation and more.
The main sign of nitrogen deficiency is a change in the color of the leaves from pale green to yellow-green and yellowContent:
Nitrogen (N) 15 % Phosphorus pentoxide (P2O5) 10 % Potassium Oxide (K2O) 30 % Iron (Fe) 0.03 % Manganese (Mn) 0.02 % Zinc (Zn), EDTA 0,02 % Copper (B) 0,02 % Boron (B) 0,02 % Molybdenum (Mo) 0,002 % -

FERT STAR
15-10-30+ME
Provider: GelAgro Group
Nationality: Bulgaria
Dose:3gm / 1L
FERT STAR 15 - 10 - 30 + ME is a powdery water-soluble fertilizer with a high nitrogen content. Nitrogen is a major building block of proteins and is part of many other important organic compounds. It is part of many biochemical processes that are essential during the growing season - leaf formation, photosynthesis, fruit formation and more. •The main sign of nitrogen deficiency is a change in the color of the leaves from pale green to yellow-green and yellow It is a water-soluble powder fertilizer with a high potassium content and has many different physiological functions:
Potassium stimulates the normal course of photosynthesis, and increases the flow of carbohydrates from the leaves to other organs of the plant, as well as the synthesis of sugars
Potassium increases the accumulation of monosaccharides in fruits and vegetables, increases their content of sugars in root crops, starch in potatoes and thickens the cell walls of grains.Content:
Nitrogen (N) 30 % Phosphorus pentoxide (P2O5) 10 % Potassium Oxide (K2O) 10 % Iron (Fe) 0.03 % Manganese (Mn) 0.02 % Zinc (Zn), EDTA 0,02 % Boron (B) 0,02 % Molybdenum (Mo) 0,002 % -

FERT STAR
10-45-10+ME
Provider: GelAgro Group
Nationality: Bulgaria
Dose: 3gm / 1L
FERT STAR 15 - 45 - 10 + ME is a powdered water-soluble fertilizer with a high phosphorus content. It is one of the main macronutrients that are essential for plant development. Phosphorus forms the root system and supports the fertility of the plants.
Potassium increases the accumulation of monosaccharides in fruits and vegetables, increases their content of sugars in root crops, starch in potatoes and thickens the cell walls of grains.
Potassium deficiency slows down development, which causes reduced yields and deterioration of product quality, significantly slows down the leaves growing - they wrinkle, acquire blue-green, purple or red-violet color. In cereals, phosphorus deficiency reduces twinning. Symptoms of phosphorus deficiency usually appear in the earliest stages of plant development.Content:
Nitrogen (N) 10 % Phosphorus pentoxide (P2O5) 45 % Potassium Oxide (K2O) 10 % Iron (Fe) 0.03 % Manganese (Mn) 0.02 % Zinc (Zn), EDTA 0,02 % Boron (B) 0,02 % Molybdenum (Mo) 0,002 % -

Storm Shadow P
18-60-80+ME+AA+Seasweeds
Provider: GelAgro Group
Nationality: Bulgaria
Dose: 2.5gm / 1L
STORM SHADOW P 18 - 60 - 18 + ME + Amino Acids and Seaweeds extract it is a mineral gel fertilizer with high phosphorus content.
It is suitable for use at the beginning of crop development, as the added amino acids and algae extract enhance the effect of micro and macronutrients.Content:
Nitrogen (N) 18 % Phosphorus pentoxide (P2O5) 60 % Potassium Oxide (K2O) 18 % Iron (Fe) 0.06 % Manganese (Mn) 0.05 % Zinc (Zn), EDTA 0,035 % Cooper (C) 0,065 % Boron (B) 0,04 % Molybdenum (Mo) 0,002 % MgO 2 % -

Storm Shadow K
20-8-60+2%MgO+ME+AA + Seasweeds
Provider: GelAgro Group
Nationality: Bulgaria
Dose: 2.5gm / 1L
Potassium is an essential nutrient for plants. It enhances plant growth and slows down their wilting, which leads to increased yields and improved product quality. Due to its influence on the course of all vital functions PDF in plants, potassium is very important not only for the quantity and quality of yield, but also for resistance to diseases, damage, low temperatures, droughts and more.
The organic ingredients of the product, amino acids and seaweed extract, help to more easily absorb micro and macronutrients, have a nutritional effect and help to more easily overcome stressful situations for plants.
It is intended for plants that are in the phase of fruit growth and ripening.Content:
Nitrogen (N) 20 % Phosphorus pentoxide (P2O5) 8 % Potassium Oxide (K2O) 60 % Manganese Oxide (MgO) 2 % Sulfur trioxide (SO2) 3.5 % Iron (Fe) 0.06 % Manganese (Mn) 0.05 % Zinc (Zn), EDTA 0,035 % Cooper (C) 0,065 % Boron (B) 0,04 % Molybdenum (Mo) 0,002 % -

Pulga X
20-0-45
12%CaO+2,5%MgO+MEProvider: GelAgro Group
Nationality: Bulgaria
Dose: 2.5gm / 1L
PULGA X 20-0-45 + 12Cao + 2MgO + TE is a gel fertilizer rich in potassium suitable for all crops that boosts fruit growth and ripening. Added trace elements, calcium, and magnesium improve the strength of the fruits and vegetables.
Potassium stimulates photosynthesis, increases the flow of carbohydrates from the leaves to other organs of the plant, as well as the synthesis of sugars. It increases: the accumulation of monosaccharides in fruits, the content of sugars in root vegetables and starch in potatoes, and strengthens the cell walls of cereals.
Lack of potassium causes many disorders in plant metabolism, which leads to a decrease in the quality of production. Externally, potassium deficiency is manifested mainly in the leaves at the bottom of the stem, as they turn yellow prematurely, starting from the edges, then they turn brown and finally the leaves die and break down, looking burnt.
Proper nutrition of plants with potassium can significantly increase the yield and quality of production.
Calcium is vital for plants' organs, especially fruits, improving their strength, transportability, and color. It also protects them against rotting.Content:
Nitrogen (N) 20 % Potassium Oxide (K2O) 45 % Calcuim Oxide (MgO) 12 % Manganese Oxide (MgO) 2,5 % Iron (Fe) 0.06 % Manganese (Mn) 0.04 % Zinc (Zn), EDTA 0,05 % Cooper (C) 0,045 % Boron (B) 0,06 % Molybdenum (Mo) 0,002 % -

Pulga Comix
Provider: GelAgro Group
Nationality: Bulgaria
Dose: 0.5:1gm / 1L
PULGA COMIX, made from 100% chelate microelements, is a specially developed crystalline fertilizer for the prevention of microelement deficiency in plants.
Its chelated form makes it 100% water soluble and absorbable by plants. The high content of microelements in our product improves plant vitality and yieldContent:
Iron (Fe) 6 % Manganese (Mn) 0.52 % Zinc (Zn), EDTA 3 % Cooper (C) 1,2 % Boron (B) 1 % Molybdenum (Mo) 0,03 % -

DalFix
Provider: GelAgro Group
Nationality: Bulgaria
Dose: 1 : 1.5gm / 1L
DALFIX is a liquid fertilizer with a rich content of amino acids and seaweed extract. It stimulates growth, flowering, ripening, and fruit growth.
DALFIX helps plants recover from stress quickly Added alginic acid enhanced plant immunity.Content:
Amino acids 21 % Seaweed extract 3,6 % Potassium Oxide (K2O) 0.52 % Alginic acid 0,52 % Iron (Fe) 1 % Cooper (Cu) 1 % -

Dropento
Provider: GelAgro Group
Nationality: Bulgaria
Dose: 1 : 1.5gm / 1L
Dropento s a liquid fertilizer with a high content of chelated Copper (EDTA) and plant amino acids, specially developed to prevent Copper deficiency.
Copper is essential for photosynthesis and respiration in plants. Its deficiency first appears on the young leaves.Content:
Amino acid 2 % Cooper (Cu) 7 % -

Perofix
Provider: GelAgro Group
Nationality: Bulgaria
Dose: 1 : 1.5gm / 1L
PERO FIX is a liquid fertilizer, a solution of boron ethanol-amine with added microelement molybdenum. It is specially developed to prevent boron and molybdenum deficiency.
The main accumulations of the trace element boron are in the flowers. That is why it is extremely important for proper flowering and fertilization.
Another major role played by the trace element boron is in the formation and growth of roots and stems in rapeseed.
Molybdenum is the trace element that is found in the smallest amounts in plants, but like the other trace elements it is essential for development and growth. Molybdenum deficiency causes yellow chlorosis of the leaves.Content:
Boron (B) 10.5 % Molybdenum (Mo) 0.5 % -

X DEFENDER
Provider: GelAgro Group
Nationality: Bulgaria
Dose: 1 : 1.5gm / 1L
X DEFENDER protects flower buds from frost damage. The product contains substances that protect against cold - the most effective natural anti-stress agent - alpha-tocophenol, and stabilizing agent - boron.
X DEFENDER protects plants for 7-3 days, depending on the weather and the stage of development. It can be applied repeatedly. It is miscible with known plant protection products, but in case, you better do a compatibility test.
X DEFENDER protects up to 2 degrees below the critical for each crop. Example: If the plant freezes at -1°C, the product will protect to -3°C.Content:
Alpha-DL-ticophenol substance protects against cold Boron (B) 2 % -

memo
Provider: organiberia
Nationality: Spain
Dose: vigtables and fruits 2 : 4 kg/acre
The 20-20-20 Garden Fertilizer is a premium, multi-purpose fertilizer that can be used at all stages of plant growth in the vegetable garden. Containing equal amounts of nitrogen (20%), phosphorous (20%) and potassium (20%) to provide a balanced formula for your vegetable plants. The nitrogen helps to promote vegetative growth, while the phosphorous and potassium stimulate a solid root system for your plants. This premium, all-purpose fertilizer can be used on any vegetable or plant in your vegetable garden. It works especially great when used early on heavy-feeding crops like tomatoes, onions or corn. It also helps to stimulate early plant growth in heavy-feeding cool crops like broccoli, cauliflower, cabbage, kohlrabi and more!
Content:
Nitrogen (N) 20 % w/w Phosphorus (P2O5) 20 % w/w Potassium (K2O) 20 % w/w -

memo
Provider: organiberia
Nationality: Spain
Dose: vigtables and fruits 2 : 4 kg/acre
A safe, high potassium, low salt fertilizer for liquid or dry application.
Sulfate of potash is an excellent high-potassium, low-chloride fertilizer providing essential nutrients that help plants resist disease and pests, ensure a longer shelf life, and produce tastier and more attractive produce without the excess chloride that can harm crops.
1: Provides high levels of potassium for increased drought, heat, wear and cold tolerance.
2: Very low salt (chloride) form of potassium for use where soil or water salinity is an issue.
Highly soluble (soluble fine grade) and can easily be mixed and sprayed by itself on in a tank mixture with other materials.Content:
Potassium (K2O) 50 % w/w Sulfur 18 % -

memo
Provider: organiberia
Nationality: Spain
Dose: vigtables 3 kg/acre
fruits 4 kg/acre
banana 6 kg/acre
Both Nitrogen and Phosphorus contained in MAP 12.61 are easily absorbed by plants.
MAP should be used at the early stage of plant development, when plants require large amounts of Phosphorus in order to stimulate root growth and, during the flowering phase, the fertilization of flowers. MAP can be mixed with other fertilizers to provide crops with the nutrients needed during the whole plant growth cycle. Do not mix the concentrated solution with Calcium-based and Magnesium fertilizers.
BENEFITS OF MAP
Fully hydrosoluble, no precipitation; Low Chlorine and sodium content;
Free of heavy metals;
Suitable for nutrient solutions;
Acidic pH;
Boosted root growth;
Enhanced crop floweringContent:
Nitrogen (N) 12 % w/w Phosphorus (P2O5) 61 % w/w -

Icon Gel
Provider: organiberia
Nationality: Spain
Dose: 3 gm/l
Potassium is an essential nutrient for plants. It enhances plant growth and slows down their wilting, which leads to increased. yields and improved product quality. Due to its influence on the course of all vital functions in plants, potassium is very important not only for the quantity and quality of yield, but also for resistance to diseases, damage, low temperatures, droughts and more.
Content:
Nitrogen (N) 11 % w/w Potassium (k2O) 46 % w/w -

Florya
Provider: organiberia
Nationality: Spain
Dose: 1 gm/l
Powder formulation based on boron and molybdenum that induces the processes of flowering, fruit setting and fattening. With FLOWRYA the deficiencies or imbalances get ready or correct the assimilation of the microelements boron and molybdenum, indispensable for the plant in the processes of flowering, fruit setting and fattening.
Content:
Phosphorus (P2O5) 24 % w/w Potassium (k2O) 11 % w/w Boron 8 % w/w Sodium molybdate 7 % w/w Molybdenum drive from molybdate (Mo) 4 % w/w -
Fungi Copper
Provider: organiberia
Nationality: Spain
Dose: 1 : 1.5 cc/l
FUNGECOBRE is a cupper solution with heptagluconic acid, it can be applied in foliar application so much and fertirrigation. The heptagluconic acid reinforces the coefficient of assimilation of the cupper facilitating the rapid penetration and the action of this micronutrient in the plant.
Content:
Copper metal (Cu) 8 % w/w Complex agent : HGA 8 % w/w Sulfer 4 % -

Indolen
Provider: organiberia
Nationality: Spain
Dose: 0 : 1 cc/l
Formulated liquid that thanks to the amino acids and phytohormones favors the root development of the plant, obtaining a better absorption of the nutrients which results in a greater production of the crop.
• Improves performance and quality of the harvests, thanks to a better rooting of the plant in the first stages of it. Anti-stress effect in adverse weather conditions, thanks to amino acids.
• Stimulating the radicular system at the beginning of the chole and in the critical periods (transplant, winter period, etc.).Content:
Nitrogen (N) 15 % w/v Amino acid 6 % w/v 1-Naphthaleneacetic acid (NAA) 1.2 % w/v Indol acid (IBA) 0.4 % w/v -

Ocanin
Provider: organiberia
Nationality: Spain
Dose: 1 cc/5 l
t is a liquid product that induces and improves the processes of flowering, fruit setting and fattening.
It is a compound of aminoacids enriched with organic acids (auxyne and citokynine).
It is really suitable for getting a faster plant reaction to the fruit fattening and ripening processContent:
6-Benzuladenine 4 % w/v 1-Naphthaleneacetic acid (NAA) 2.4 % w/v NAA Amide (Naftylacetamide acid) 1.6 % w/v -

memo hume
Provider: organiberia
Nationality: Spain
Dose: 1 kg/5000 m2
HUMY TOP is a natural humic conditioner, obtained from American Leonardite and presented as a soluble powder, that improves the physical, chemical and biological characteristics of the soil. The use of the product allows the medium (soil) in which the crops are grown to be improved and transformed, facilitating the availability and assimilation of the nutrients by the crops.
Content:
Total Humic Extract (T.H.E) 72 % w/w (dry base) Humic acids 56 % w/w (dry base) Fulvic acids 16 % w/w (dry base) Potassium (K2O) 10 % w/w (dry base) -

powersta
Provider: organiberia
Nationality: Spain
Dose: 1 : 2kg/acre
POWERSTA is a product with a triple function:
1. Correct deficiencies in calcium, manganese and zinc, especially in soils where these products are not as assimilated by the plant.
2. With organic acids that contribute, are favored physiological processes involved in the growth of the fruit
3. Applying POWERSTA via irrigation, the root system is strengthened, helping to regrow the plant, which is very beneficial agronomic stressful situations or when we want to force the plant to produce more.
It takes the form of microgranules by a product which is very soluble in water. These microelements are complexed by organic acids that facilitate rapid absorption of these nutrients.Content:
Fulvic acid 36 % Calcium acetate 11 % Sulfr 6.10 % Mn 6 % Glycine 5 % Zn 5.5 % Enzims 0.10 % -

uenixema
Provider: organiberia
Nationality: Spain
Dose: 1 : 2kg/acre
It is a formulated biological of fungi. that they controls nematodes type meloidogyne sp., radopholus sp., helicotilenchus sp.,
pratylenchus sp. and globodera sp. These fungi parasitizes the 3 phases of nematodes (eggs, larves and adults) that coexist with the horticultural cultures.
It also has a stimulating effect of the root, reinforcing the secondary root growth.Content:
Potassium (K2O) 45 % Sulfer 16.1 % Maltodextrin polysaccharide 10 % Microbial comlex composed for fungi improve agronomics condition (5x106 spores/gram) -

Demostrain
Provider: organiberia
Nationality: Spain
Dose: 1 : 2kg/acre
Iron EDDHA chelated, presented in the form of soluble micro@granules, indicated for the prevention and correction of iron chlorosis under all manner of conditions, including calcareous and alkaline soils.
DEMOSTRAIN avoids the deficiency of iron in fruit trees, vegetables and flowers for effect of the pH that there can accentuate for excess of water, lack of aeration of the soil or for the action antagonist of other microelements.Content:
Iron (Fe) 6 % w/w Ortho-Ortho 4.8 %
what is MV10 technology?
It is a package of vitamins MV10 specially developed from Mivena Holland that includes components that enhance the efficiency and speed of delivery of nutrients and raise the efficiency of plant assimilation to them within the targeted places. This shows very positive results on plant health and vitality
what are the components of MV10 ?
Because the MV10 is a patent technology owned by Mivena Holland, we will provide just the major components of the technology components which are
1.A group of chelating compounds that improve the absorption of nutrients in the case of using the foliar spray (fertigation) method.
2.A compound that works to control the pH of the spray solution in order to achieve a benefit of up to 100% preventing the elements of the total.
3.A group of vitamins that increase the metabolism process, which enhances the ability and efficiency of the leaves for absorption and allowing the nutrients reach their targets.
4.A group of functional elements that assist in the absorption of NPK in the case of using ground irrigation programs.
5.A group of elements that reduces abiotic stress and thus preserve crops in a healthy and productive.


















